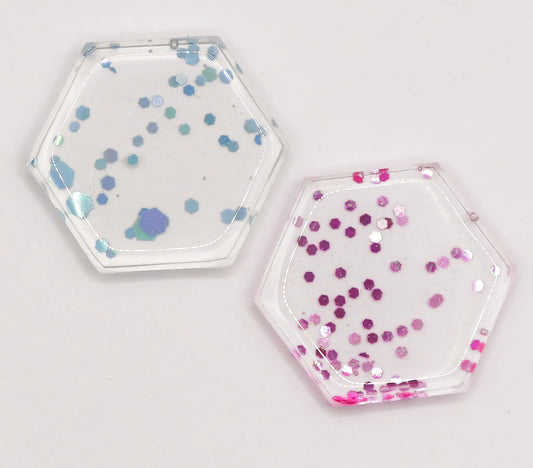
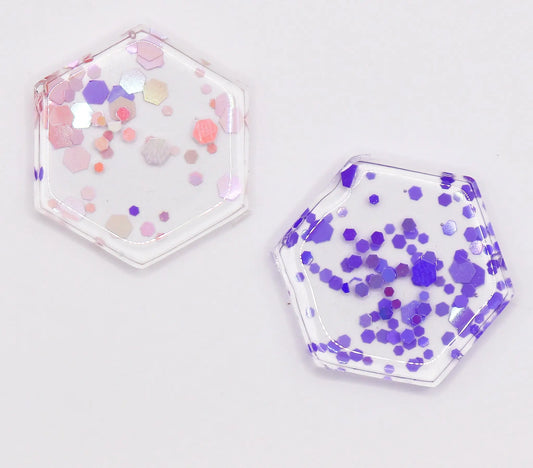

Sarah is amazing, not only does she make some good qualtiy stuff but she’s the sweetest too. I ordered some markers, and a badge reel that the system had accidently listed as $5. Not only was she kind enough to still send a badge reel she CUSTOMISED IT into my preffered colour AND with my name on it. And then when the packaged arrived it was packaged so cutely and also had a pack of FREE marker adhesive. She’s honestly the best and i will totally be getting more markers from her in the future!
Nice product , prompt delivery and good communication all the way
so beautiful!! I love them so much